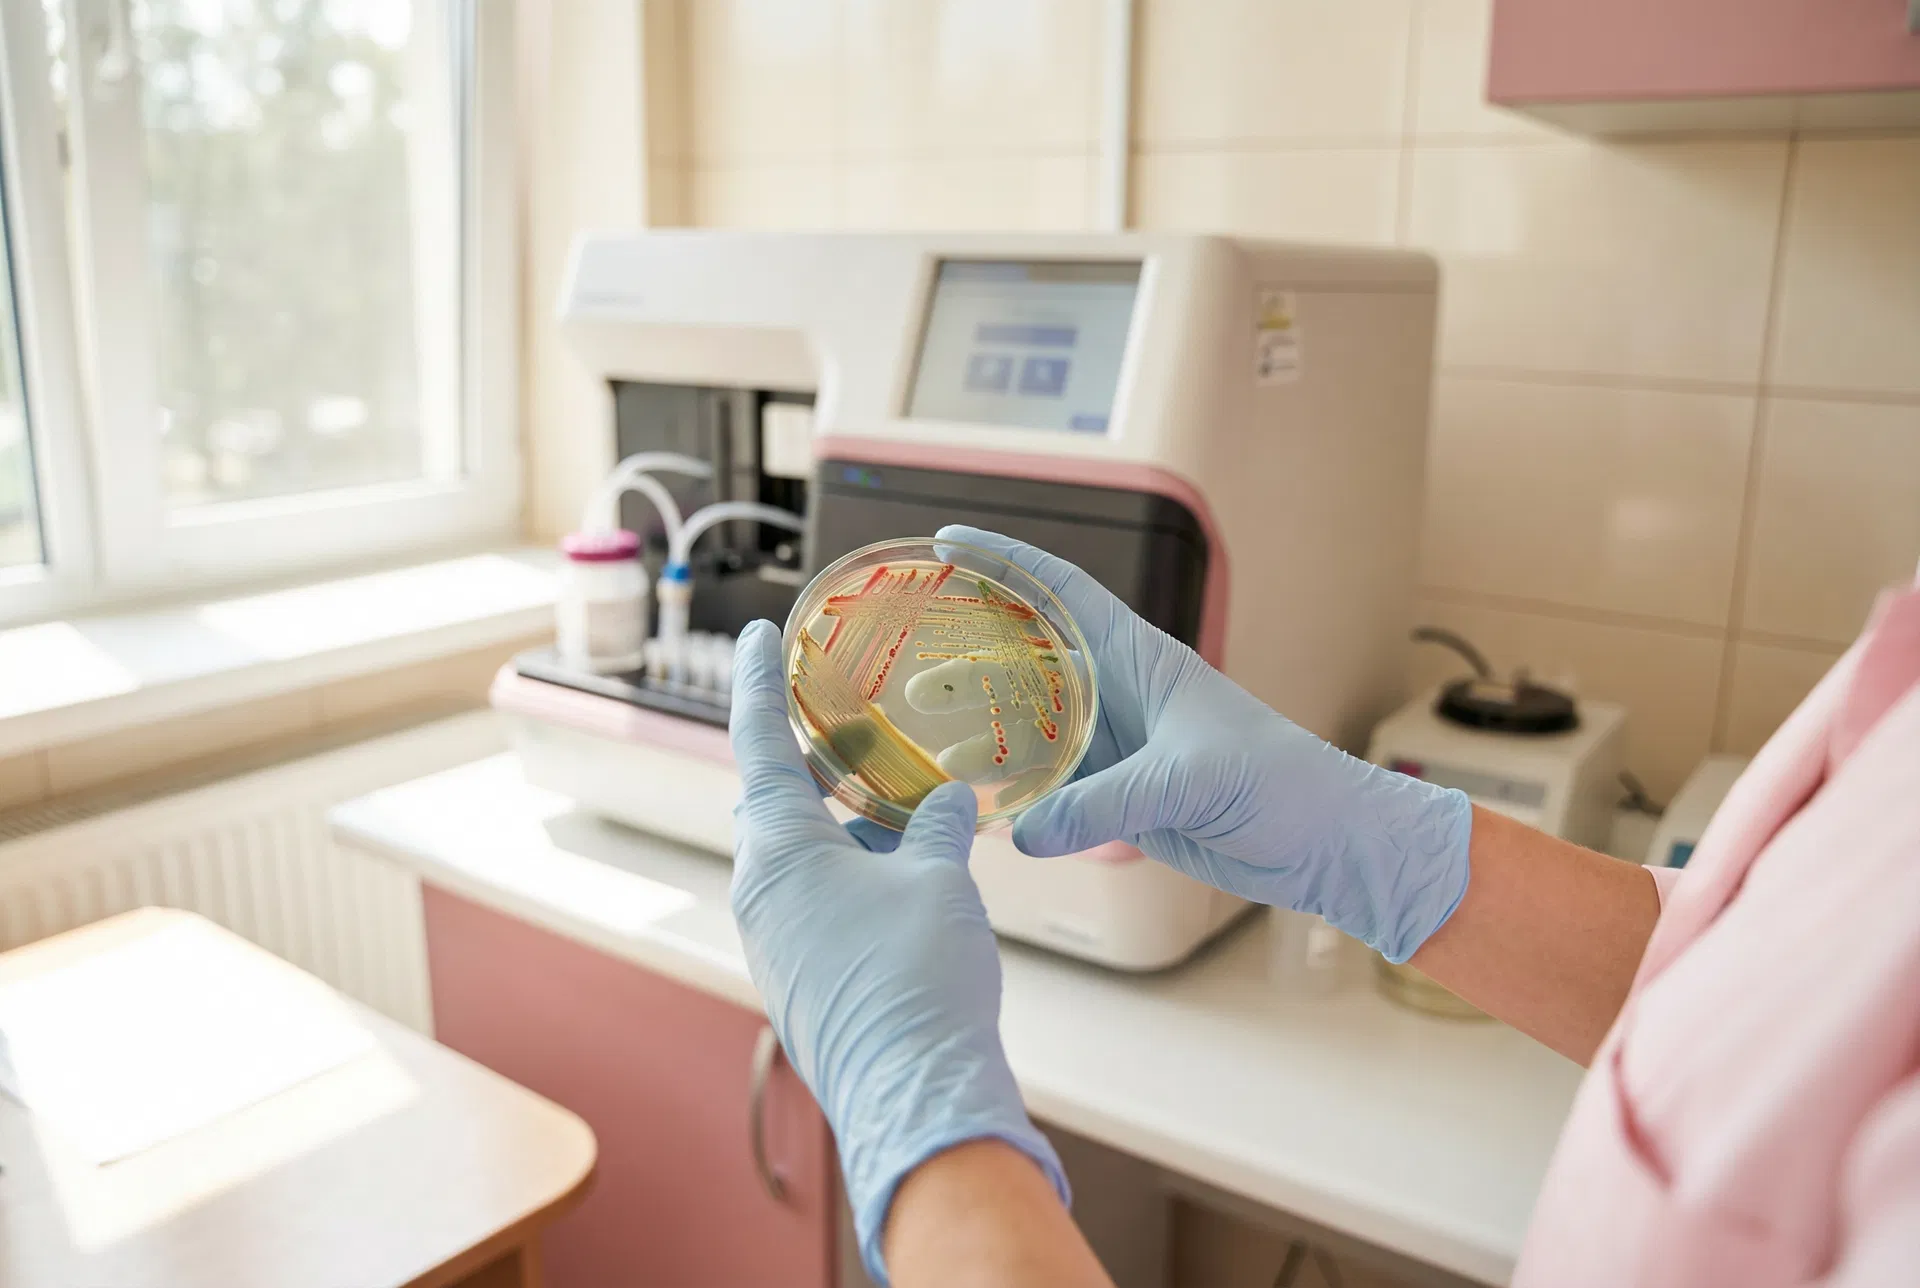

Choosing between Microba, Zoe, and GI-MAP is one of the most common questions Elena Rolt IFMCP, BANT, CNHC receives in practice. Each test measures something meaningfully different, and selecting the wrong one can mean spending hundreds of pounds on data that does not answer your clinical question. This guide provides an honest, methodology-first comparison to help you make the right choice.
Quick Verdict
For most people with persistent gut symptoms — bloating, IBS, fatigue, food sensitivities — GI-MAP is the most clinically actionable test because it directly identifies pathogens, dysbiosis markers, and intestinal health indicators. Microba is the gold standard for microbiome diversity analysis and is ideal when the question is about long-term microbiome health and personalised dietary strategy. Zoe is a consumer-friendly option best suited to people who are generally well and want dietary optimisation data rather than clinical answers.
Comparison at a Glance
| Feature | Microba | Zoe | GI-MAP | |
|---|---|---|---|---|
| Technology | Shotgun metagenomics | Shotgun metagenomics + metabolic testing | qPCR (quantitative PCR) | |
| What it measures | Microbiome species + functional genes | Microbiome + blood sugar + blood fat | Pathogens, parasites, bacteria, viruses, intestinal markers | |
| Pathogen detection | Limited | None | Comprehensive | |
| Practitioner interpretation | Recommended | Not required | Strongly recommended | |
| Approximate cost (UK) | £295–£395 | £299 | £299–£399 | |
| Turnaround | 4–6 weeks | 4–6 weeks | 2–3 weeks | |
| Best for | Microbiome diversity, long-term health | Dietary optimisation, general wellness | Symptoms, infections, dysbiosis, IBS |
Microba: The Microbiome Depth Test
Microba uses shotgun metagenomics — the most comprehensive sequencing technology available — to identify bacterial species at a resolution that 16S rRNA panel tests cannot match. It reports on over 20,000 microbial species and provides functional gene analysis, meaning it can tell you not just which bacteria are present but what those bacteria are doing metabolically.
Microba's strength is breadth and depth of microbiome characterisation. Its reports identify keystone species, diversity indices, and functional pathways relevant to inflammation, short-chain fatty acid production, and metabolic health. The limitation is that it does not detect pathogens, parasites, or intestinal health markers such as calprotectin or secretory IgA. If your question is 'do I have an infection or parasite?' Microba will not answer it.
Microba is most useful for people who want to understand their long-term microbiome health, optimise their diet for their specific bacterial ecosystem, or track microbiome changes over time. It is also the test Elena uses most frequently as part of the Gut Microbiome Testing and Rebalancing programme.
Zoe: The Consumer Metabolic Test
Zoe combines shotgun metagenomics with continuous glucose monitoring and blood fat measurements to produce a personalised dietary score system. Its scientific foundation is solid — the PREDICT studies that underpin Zoe are peer-reviewed and demonstrate that individual metabolic responses to food vary significantly even between identical twins.
The practical limitation of Zoe is that its interpretation is automated and consumer-oriented. The test is designed to be self-managed, which makes it accessible but limits its clinical utility for people with complex symptoms. Zoe cannot diagnose IBS, SIBO, inflammatory bowel disease, or food allergies, and its microbiome analysis, while technically sound, is presented in simplified form rather than as a clinical report.
Zoe is a reasonable starting point for generally healthy people who want to understand how their body responds to different foods. For anyone with persistent symptoms, it is not the right first test. See our full Zoe gut health test review for a detailed analysis.
GI-MAP: The Clinical Symptoms Test
GI-MAP (Gastrointestinal Microbial Assay Plus) uses quantitative PCR technology to detect and quantify specific pathogens, parasites, bacteria, viruses, and intestinal health markers. Unlike metagenomics tests, GI-MAP is designed specifically for clinical diagnosis and symptom investigation.
The test screens for bacterial pathogens including H. pylori, Campylobacter, Salmonella, and Shigella; parasites including Cryptosporidium, Giardia, and Entamoeba; opportunistic bacteria; and intestinal health markers including calprotectin (inflammation), secretory IgA (immune function), and zonulin (intestinal permeability).
GI-MAP is the most clinically actionable test for people with active symptoms. It directly answers the question 'what is causing my symptoms?' rather than simply describing the microbiome ecosystem. For people with IBS, bloating, persistent diarrhoea or constipation, suspected SIBO, food sensitivities, or fatigue with a digestive component, GI-MAP is typically the most appropriate starting point. Elena frequently uses GI-MAP as part of the Advanced Functional Health Assessment to identify root causes before designing a treatment protocol.
Which Test Is Right for Your Symptoms?
| Symptom or Goal | Recommended Test | |
|---|---|---|
| IBS, bloating, diarrhoea, constipation | GI-MAP | |
| Suspected infection or parasite | GI-MAP | |
| Fatigue with digestive symptoms | GI-MAP | |
| Food sensitivities and intolerances | GI-MAP | |
| Optimising microbiome diversity | Microba | |
| Long-term gut health monitoring | Microba | |
| General dietary optimisation (no symptoms) | Zoe | |
| Understanding metabolic response to food | Zoe |
The Case for Practitioner-Guided Testing
All three tests produce data that requires interpretation. GI-MAP results in particular require clinical context — elevated H. pylori, for example, does not automatically mean treatment is required; the clinical picture, symptom severity, and strain virulence all matter. Microba's functional gene data is similarly complex without a practitioner to contextualise it against your symptoms and health history.
Ordering a test without a practitioner to interpret it is a common and costly mistake. Elena offers a free discovery call to help you determine which test is most appropriate for your situation before you spend anything.
Frequently Asked Questions
Can I do more than one test at the same time?
Yes, and in some cases it is clinically appropriate to combine tests. GI-MAP and Microba are complementary — GI-MAP identifies what is wrong while Microba characterises the broader ecosystem. Elena will advise on the most cost-effective testing strategy during your initial consultation.
Are these tests available through the NHS?
Standard NHS stool tests screen for a limited range of pathogens and are not equivalent to GI-MAP, Microba, or Zoe. For a full comparison, see our guide to NHS gut testing vs private functional testing.
How long do results take?
GI-MAP typically returns results in two to three weeks. Microba takes four to six weeks. Zoe takes four to six weeks including the at-home testing phase.
When to Seek Practitioner Support
If you have persistent symptoms lasting more than four weeks, symptoms that are worsening, unexplained weight loss, blood in your stool, or a family history of bowel disease, you should see your GP before ordering any private test. Private gut testing is complementary to, not a replacement for, NHS investigation when red-flag symptoms are present.
Take the Next Step
Book a free discovery call with Elena to discuss which test is most appropriate for your symptoms and health goals. She can advise on the right test, order it on your behalf, and provide a full clinical interpretation of your results as part of a personalised gut health programme.